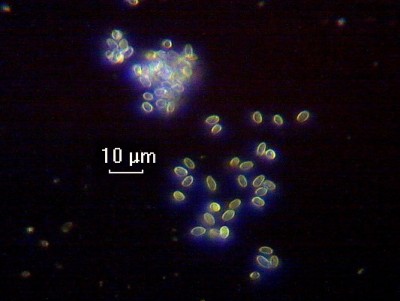
Как приготовить постоянный микропрепарат? 30 Октябрь 2014 22:06 Как приготовить постоянный микропрепарат? 30 Октябрь 2014 22:06

|
| Автор |
Сообщение |
|
Игорь Загинайло
|
|
Регистрация: 21 окт 2014 Посты: 83 Откуда: Одесса
|
СТ иногда проскакивают на Aukro. Несколько месяцев назад мне удалось там приобрести СТ-11 по вменяемой цене. Он крепится так же, как и СТ-12. Правда, СТ-11 сделан для микроскопов, у которых не револьвер, а щипцовое устройство для смены объективов, поэтому иногда неработающий объектив может упираться в винт подачи; проблема решается выбором порядка размещения объективов в револьверном устройстве.
|
|
|
|
|
|
|
Igor Tkachenko
|
|
Регистрация: 29 окт 2014 Посты: 31 Откуда: Киев
|
сегодня на фруктозной монтирующей среде сделал постоянный препарат водорослей от которых пытаюсь избавиться в аквариуме, увеличение 600х  Просмотров: 2693
хочу попробовать сделать несколько снимков и программно увеличить резкость, но пока не придумал как закрепить айфон которым фоткаю, т.к. нормальный объектив с камерой для хобби слишком дорого 
|
|
|
|
|
|
|
Игорь Загинайло
|
|
Регистрация: 21 окт 2014 Посты: 83 Откуда: Одесса
|
Igor Tkachenko писал(а): сегодня на фруктозной монтирующей среде сделал постоянный препарат водорослей от которых пытаюсь избавиться в аквариуме Для первой попытки неплохо. А какое у Вас освещение? Для МБИ лучше всего использовать ИО-19 и настраивать свет по Келеру. Вы до помещения в монтирующую среду фиксировали препарат? Обычно фиксация разрушет (растворяет) хлорофилл в хлоропластах. Я когда-то читал, что для неокрашенных и нефиксированых препаратов может использоваться монтирующая среда на основе жидкого стекла (обычного конторского силикатного клея) и глицерина. Сохраняет хлорофилл. На выходных постараюсь поднять свои записи, выложу "рецепт". Igor Tkachenko писал(а): ...увеличение 600х... Термин "увеличение" в микроскопии относится только к визуальным наблюдениям. Запись 600х означает, что изображение предмета на сетчатке глаза в 600 раз больше натурального. А в фотографии принято указывать масштаб. На "твердых копиях" обычно писалось что-то вроде 600:1. Сейчас, когда размер изображения цифрового фото зависит от диагонали монитора, это потеряло смысл. Теперь принято просто показывать на снимке размер масштабного отрезка, как тут, напрмер: viewtopic.php?f=11&t=8887&start=40#p34208. Разместить масштабный отрезок на снимке можно с помощью специальной программы обработки микрофотоснимков. Я использую Micam v1.4, эта версия доступна без лицензионного ключа. Igor Tkachenko писал(а): ...пока не придумал как закрепить айфон которым фоткаю... Есть специальные адаптеры для айфонов, крепят девайс на окулярной трубке. Можно поискать на еВау. Тоже видел, кажется на http://www.microscopy-uk.org.uk/, как народ делает эти адаптеры самостоятельно. Если на выходных найду - дам ссылку.
|
|
|
|
|
|
|
Артем Астроскоп
|
|
Регистрация: 05 дек 2011 Посты: 1255
|
Igor Tkachenko писал(а): сегодня на фруктозной монтирующей среде сделал постоянный препарат водорослей от которых пытаюсь избавиться в аквариуме, увеличение 600х JSrDaEuG2rU[1].jpg хочу попробовать сделать несколько снимков и программно увеличить резкость, но пока не придумал как закрепить айфон которым фоткаю, т.к. нормальный объектив с камерой для хобби слишком дорого  У Вас попал пузырёк воздуха в препарат, у меня та же проблема.
|
|
|
|
|
|
|
Артем Астроскоп
|
|
Регистрация: 05 дек 2011 Посты: 1255
|
Igor Tkachenko писал(а): сегодня на фруктозной монтирующей среде сделал постоянный препарат водорослей от которых пытаюсь избавиться в аквариуме, увеличение 600х JSrDaEuG2rU[1].jpg хочу попробовать сделать несколько снимков и программно увеличить резкость, но пока не придумал как закрепить айфон которым фоткаю, т.к. нормальный объектив с камерой для хобби слишком дорого  Что касается крепления телефона, подходит к любой модели! Правда цена высокая. https://astroscope.com.ua/adapter_ca ... /35234.htm Есть ещё вариант. Находите пластиковую, а лучше алюминиевую трубку, внутренний диаметр трубки = внешнему диаметру окуляра, хотя не критичен и маленький зазор. Отрезаем 2-3 см. Сверлим 3-и отверстия с равным промежутком и метчиком нарезаем в них резьбу. Там будут стопорные винты, которые зафиксируют трубку на окуляре. Саму трубочку приклеиваем суперклеем к чехлу от телефона и готово. Одеваете сей девайс на окуляр, винтами фиксируете его положение.
|
|
|
|
|
|
|
Артем Астроскоп
|
|
Регистрация: 05 дек 2011 Посты: 1255
|
Игорь Загинайло писал(а): СТ иногда проскакивают на Aukro. Несколько месяцев назад мне удалось там приобрести СТ-11 по вменяемой цене. Он крепится так же, как и СТ-12. Правда, СТ-11 сделан для микроскопов, у которых не револьвер, а щипцовое устройство для смены объективов, поэтому иногда неработающий объектив может упираться в винт подачи; проблема решается выбором порядка размещения объективов в револьверном устройстве. Игорь, у Вас есть опыт установки "не родных" темнопольных конденсоров на микроскоп?
|
|
|
|
|
|
|
Igor Tkachenko
|
|
Регистрация: 29 окт 2014 Посты: 31 Откуда: Киев
|
Игорь Загинайло, спасибо за советы и подсказки! жду Ваших записей о монтирующей среде на силикате натрия и глицерине  пока еще не определился чего сегодня хочу больше - поковыряться в программке Micam или пойти в кино на Лють (Fury), давно ждал  освещение светодиодный фонарик за 25 грн (зеркало купил, получу только сегодня) про то как настраивать свет по чуваку Келеру почитаю, еще раз спасибо за инфу! препарат не фиксировал - подумал по принципу варенья - в сахаре фрукты не портятся, то и во фруктозе ненавистная аквариумная "нитка" тоже не испортится. про масштаб, масштабный отрезок понял, надо почитать как посчитать этот отрезок, ведь фото делаю держа в руке на некотором расстоянии от окуляра и соотв. размер объекта на фото гуляет. Воздух попал потому что монтирующую среду приготовил за 15 мин до фиксации и в растворе были пузырьки воздуха, дегазировал в вакууме мин 10, дольше терпеть не мог  там кстати еще видно синезеленые водоросли не в фокусе. с алюминиевой трубкой надо что-то подумать, действительно должно получится 
|
|
|
|
|
|
|
Игорь Загинайло
|
|
Регистрация: 21 окт 2014 Посты: 83 Откуда: Одесса
|
Артем Астроскоп писал(а): Игорь, у Вас есть опыт установки "не родных" темнопольных конденсоров на микроскоп? Нет у меня такого опыта. И родных (для МБИ/МБР/МБД и БИОЛАМ-Р/Д/С) ЛОМОвских темнопольных конденсоров у меня тоже нет. Сделал себе темнопольные вкладки для объективов 20х/0.4 и 40х/0.65 в держатель фильтра обычного конденсора. Конечно, это не то, что кардиоконденсор ОИ-13 Но, должен сказать, что эксперименты с темным полем показали: требования к образцам на порядок выше, чем в светлом поле; они должны быть ОЧЕНЬ ТОНКИМИ и в них не должно быть НИКАКИХ ПОСТОРОННИХ ВКЛЮЧЕНИЙ: все включения светятся, а если не в фокусе - дают светящиеся кольца или просто фон - см. иллюстрацию (объектив 40х/0,65). А какие могут быть проблемы с "не родными" конденсорами? а) посадочный диаметр - тут дешевле найти "родной", чем заниматься токаркой для посадки б) рабочее расстояние (от фронтальной линзы конденсора до предметного стекла) - но это скорее теоретическая проблема, конденсор должен перемещаться по вертикали. Важно, чтобы темнопольный конденсор был иммерсионным. Сухие конденсоры могут обеспечить темное поле в объективах с апертурой до 0.7, т.е. 40х, не более. Гораздо интереснее темного поля фазовый контраст. Причем фазоконтрастные конденсоры могут использоваться для организации темного поля с низко- и среднеапертурными объективами.
Комментарий к файлу: Микробы из йогурта
 Просмотров: 2662
|
|
|
|
|
|
|
|
Игорь Загинайло
|
|
Регистрация: 21 окт 2014 Посты: 83 Откуда: Одесса
|
Igor Tkachenko писал(а): ...про масштаб, масштабный отрезок понял, надо почитать как посчитать этот отрезок... Нужно отснять объект известного размера. Обычно это специальная шкала - "объект-микрометр", у нас выпускалось 2 разновидности: ОМП (для проходящего света) и ОМО (для отраженного), но и последний достаточно просвечивается хорошим осветителем, так что если попадется незадорого, то его можно брать. Igor Tkachenko писал(а): ...Воздух попал потому что монтирующую среду приготовил за 15 мин до фиксации и в растворе были пузырьки воздуха, дегазировал в вакууме мин 10, дольше терпеть не мог ... Часто рекомендуют дегазировать сам объект (например, листовую пластинку или стебель) перед проводками. Igor Tkachenko писал(а): ...с алюминиевой трубкой надо что-то подумать, действительно должно получится Вспомнил, что есть такие штуковины - автодержатели для мобильников. Найдите самый дешевый автодержатель для своей модели, отделите ложе от ножки, и именно его, а не чехол, монтируйте; ясно дело - напротив камеры просверлить дырку. А вот на окулярную трубку лучше надеть не другую трубку (нужен диаметр 25 мм, но в разных поколениях монокулярных насадок толщина эмали разная, на одной трубка будет сидеть сверхплотно, на другой - может болтаться). Лучше делать разрезную гайку, можно даже из дерева (дуб, бук). Ну и предусмотреть юстировку ложа для совмещения оптических осей - не клеить, а крепить винтами через отверстия бОльшего диаметра, чтобы ложе "ходило"; поймав совмещение - затянуть. В общем, если есть руки, то можно сэкономить почти сотню баксов. А про силикатную среду посмотрю, как обещал, на выходных. И кстати о водорослях: зеленая нитчатая и диатомовая, обе - живые, в морской воде (временный препарат, сорри за оффтоп), объектив 90х.
Комментарий к файлу: В морской воде
Просмотров: 2660
|
|
|
|
|
|
|
|
Igor Tkachenko
|
|
Регистрация: 29 окт 2014 Посты: 31 Откуда: Киев
|
здорово! скажите, такое фото на ЛОМОвском иммерсионном объективе получится или это у Вас какой-то модный план-апохромат? какое увеличение окуляра? у меня был окуляр с сеткой, но не уследив обнаружил его у племянницы в песочнице, в общем больше он не окуляр позавчера приготовил монтирующую среду на основе канифоли и ксилола (1 г к 1.5 мл), сначала вся канифоль растворилась, но сегодня утром обнаружил что часть выкристаллизовалась. видимо таким насыщенным раствором пользоваться и буду, т.к. вязкость и так маловата, а концентрацию больше чем у насыщенного раствора получить нельзя.
|
|
|
|
|
|
|
|
Кто сейчас на конференции
| Сейчас этот форум просматривают: нет зарегистрированных пользователей и гости: 2 |
|
Вы не можете начинать темы Вы не можете отвечать на сообщения Вы не можете редактировать свои сообщения Вы не можете удалять свои сообщения Вы не можете добавлять вложения
|
Карта XML карта RSS лента Список каналов
|
|